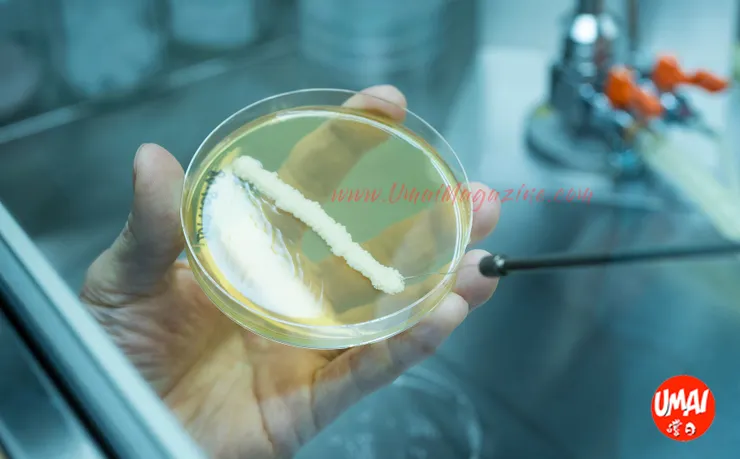
vocus｜新世代的創作平台

也許大家對日本酒界大前輩 秋山裕一 認識不深,但大家一定聽過他畢生心血的名字、歷史首枚「低發泡性酵母」酵母菌株~「協會701號」。

秋山裕一(Yuichi Akiyama)
1924年出生於山梨縣的酒造家庭。1947年畢業於東京大學,在被尊稱為「日本酒博士」的坂口謹一郎教授其發酵科學課下學習了5年。及後加入國家稅務總局釀造實驗室,並於1982年退休後,他擔任了協和発酵、醸造協会、醸造学会会長的主席,並於2006年退休。在此期間,他獲得了日本科技署署長獎,紫絲帶獎和社會獎。著有影響著日本酒界的『日本酒』、『酒造りの不思議』等經典書籍。



他經過無數次的反覆試驗,終於,在昭和44年(1969年),這個被他稱為「泡沫法」的作業方式產生了一種不太起泡的新酵母菌株。秋山稱它為「協會701號」。它帶華麗香味,適合廣泛用於吟釀酒及普通釀造酒。在成功篩選出此種「低發泡性酵母」四十多年後的今天,仍然廣為日本釀酒業者採用。
協會系酵母菌種由來
日本在明治維新 (1860年代到1880年代) 推動西化改革之後,清酒釀造從1895年開始使用了清酒酵母,但是當時綜合西方科學的清酒釀造技術尚未成熟,常常出現醪的發酵不完全,遲遲無法生長成清酒狀態。為了改善此窘境,1904年日本政府成立了酒類綜合研究所,並以酒質的上升為共同目標,每年開設了全國新酒評鑑會,鼓勵從業者改善釀造技術。
每年這樣比賽下來,酒質穩定、常獲獎的藏元就成了注目焦點,研究人員就會去找出這些藏元的共通點,除了品質佳的釀造用水及酒米、杜氏的技術之外,研究人員還在這些藏元的酒藏內,發現了發酵力旺盛的酵母菌種。
日本釀造協會將各藏元的優良酵母集中培養,再賣給各家藏元使用。依照發表順序,給每種酵母「協會X號」的名稱。

協會系酵母
最初,酵母是從「醪」裡被提煉出來,現今大部分的清酒酵母是由日本釀造協會所販賣,稱為協會系酵母,最常被藏元使用的是7號及9號。酵母還細分為「有泡酵母」及「無泡酵母」,代號後面有加上01的則是「無泡酵母」。
低發泡性酵母
基本上「有泡酵母」及「無泡酵母」性質一樣,只是分有泡或無泡而已。要特別說明的是,「無泡酵母」並不代表完全無泡,而是指在釀造過程中,起泡較少,不需要另外添購消泡器,並且可以增加20%至30%的產量。所以,UMAI 編輯們偏向稱它們為「低發泡性酵母」。


光是酵母就如此多種,下次各位在選購清酒時,不妨看看背標的酵母種類,再與自己感受到的香氣作對照,可以增加更多品嚐清酒的樂趣 !
__________________________
如果喜歡我們的文章,歡迎追蹤加訂閱我們的專欄。你的支持,是我們持續寫作的動力!:)
⭐️⭐️⭐️⭐️⭐️⭐️⭐️⭐️⭐️⭐️⭐️
👀睇唔到最新資訊?
咁就要將 #UMAI 專頁設定為「搶先看」喇!
📍UmaiMagazine.com
⭕ Online Shop:https://bit.ly/2N7GtKA
⭕ IG : https://bit.ly/2MHhFhr
⭕ Twitter : https://bit.ly/2wPezNF
⭕ YouTube : https://bit.ly/2WGgun3




















